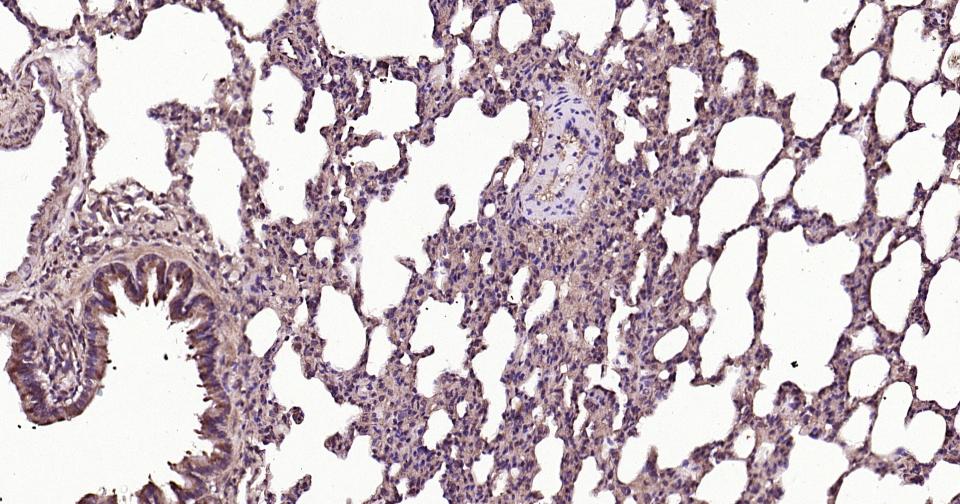
RAB5B Rabbit pAb(bs-11783R)-50

相关产品推荐更多 >

phospho-MAP3K8 (Ser400) Rabbit pAb, BF350 conjugated(bs-3454R-BF350)-100ul
¥2980
Complement C3 Goat pAb(bs-0367G)-50ul/100ul/200ul
¥1180
DLL1 Rabbit pAb, Biotin conjugated(bs-7345R-Bio)-100ul
¥2980
PDGF-B Rabbit pAb, APC conjugated(bs-0185R-APC)-100ul
¥2980
Ly-6G Rabbit pAb(bs-41202R)-50ul/100ul/200ul
¥1180
万千商家帮你免费找货
0 人在求购买到急需产品
- 详细信息
- 文献和实验
- 技术资料
- 应用范围:
产品信息以Bioss网站为准
- 规格:
50ul/100ul/200ul
| 规格: | 50ul | 产品价格: | ¥1180.0 |
|---|---|---|---|
| 规格: | 100ul | 产品价格: | ¥1980.0 |
| 规格: | 200ul | 产品价格: | ¥2800.0 |
| 产品编号 | bs-11783R |
| 英文名称 | RAB5B Rabbit pAb |
| 中文名称 | RAS相关蛋白Rab5B抗体 |
| 英文别名 | Rab 5b; Rab5 b; RAB5B, member RAS oncogene family; Ras related protein Rab 5B; RAB5B_HUMAN. |
| 产品应用 | IHC-P=1:100-500, IHC-F=1:100-500, IF=1:100-500, ELISA=1:5000-10000 Not yet tested in other applications. |
| 交叉反应 | Human, Mouse, Rat |
| 抗体来源 | Rabbit |
| 免疫原 | KLH conjugated synthetic peptide derived from human Rab5b |
| 亚型 | IgG |
| 性状 | Liquid |
| 纯化方法 | affinity purified by Protein A |
| 克隆类型 | Polyclonal |
| 理论分子量 | 24 kDa |
| 浓度 | 1mg/ml |
| 储存液 | 0.01M TBS (pH7.4) with 1% BSA, 0.02% Proclin300 and 50% Glycerol. |
| 研究领域 | Neuroscience > Neurology process > Neurodegenerative disease > Parkinson's disease Neuroscience > Neurotransmission > Secretory Vesicles > Rabs Signal Transduction > Protein Trafficking > Vesicle Transport > Regulation Signal Transduction > Signaling Pathway > G Protein Signaling > Small G Proteins > Ras Family |
| 亚基 | Binds EEA1. Interacts with RIN2 and RIN3, which probably regulate its pathway, possibly by acting as GEFs. |
| 亚细胞定位 | Cell membrane; Lipid-anchor; Cytoplasmic side. Early endosome membrane; Lipid-anchor. Melanosome. Note=Enriched in stage I melanosomes. |
| 相似性 | Belongs to the small GTPase superfamily. Rab family. |
| 功能 | Rab5b is a member of the Rab family of small (monomeric) G proteins. Like other small G proteins, Rab5b switches between an inactive, GDP-form and an active, GTP-bound form. GDP/GTP exchange factors (GEFs) catalyse the conversion from the GDP-bound form to the GTP-bound form, while GTPase-activating proteins (GAPs) catalyse GTP hydrolysis to GDP. Rab5b is involved in endocytosis and recycling of cell surface molecules. It interacts with RIN2 and RIN3, which regulate its function, possibly by acting as GEFs. Knockdown of Rab5b abolished group I metabotropic glutamate receptor (mGluR)-mediated neuroprotection. Furthermore, Rab5b interacts with LRRK2, the defective gene at the PARK8 locus that results in Parkinson's disease. Roles for Rab5b in neurodegenerative disease, neuroprotection, and synaptic plasticity have been suggested. |
| 保存条件 | Shipped at 4℃. Store at -20℃ for one year. Avoid repeated freeze/thaw cycles. |
| 注意事项 | This product as supplied is intended for research use only, not for use in human, therapeutic or diagnostic applications. |
| 背景资料 | The Ras-related superfamily of guanine nucleotide binding proteins, which includes the R-Ras, Rap, Ral/Rec and Rho/Rab subfamilies, exhibit 30-60% homology with Ras p21. Accumulating data suggests an important role for Rab proteins, either in endocytosis or in biosynthetic protein transport. The transport of newly synthesized proteins from the endoplasmic reticulum to various stacks of the Golgi complex and to secretory vesicles involves at each stage the movement of carrier vesicles, a process that appears to involve Rab protein function. The possibility that Rab proteins might also direct the exocytosis from secretory vesicles to the plasma membrane is supported by the observation that in yeast, the SEC4 protein, which is 40% homologous to Rab proteins, is associated with secretory vesicles. At least eight members of the Rab subfamily have been identified, each of which is found at a particular stage of a membrane transport pathway. |
| 应用 | 推荐稀释比例 |
| {IHC-P} | {1:100-500} |
| {IHC-F} | {1:100-500} |
| {IF} | {1:100-500} |
| {ELISA} | {1:5000-10000} |

风险提示:丁香通仅作为第三方平台,为商家信息发布提供平台空间。用户咨询产品时请注意保护个人信息及财产安全,合理判断,谨慎选购商品,商家和用户对交易行为负责。对于医疗器械类产品,请先查证核实企业经营资质和医疗器械产品注册证情况。
文献和实验[IF={{ 15.8 }}] {Zhenyu Wang. et al. Morphology-Mediated Tumor Deep Penetration for Enhanced Near Infrared II Photothermal and Chemotherapy of Colorectal Cancer. ACS NANO. 2024;18(41):28038–28051} {IF} {Mouse}
技术资料暂无技术资料 索取技术资料





